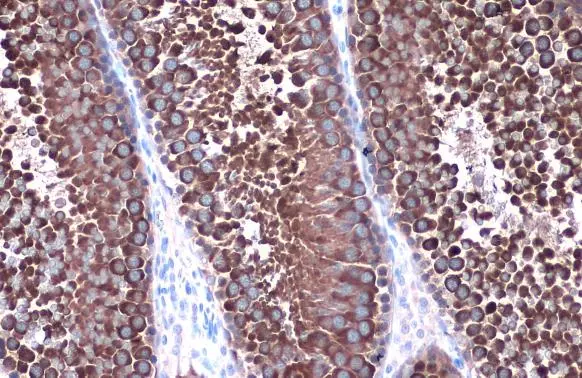
Hsp90 alpha antibody detects Hsp90 alpha protein at cytoplasm by immunohistochemical analysis. Sample: Paraffin-embedded rat testis. Hsp90 alpha stained by Hsp90 alpha antibody (GTX109753) diluted at 1:1000. Antigen Retrieval: Citrate buffer, pH 6.0, 15 min

Whole cell extract (30 μg) was separated by 7.5% SDS-PAGE, and the membrane was blotted with Hsp90 alpha antibody (GTX109753) diluted at 1:1000. The HRP-conjugated anti-rabbit IgG antibody (GTX213110-01) was used to detect the primary antibody.
Hsp90 alpha antibody
GTX109753
ApplicationsImmunoFluorescence, ImmunoPrecipitation, Western Blot, ImmunoCytoChemistry, ImmunoHistoChemistry, ImmunoHistoChemistry Paraffin
Product group Antibodies
ReactivityDrosophila, Human, Monkey, Mouse, Rat, Other Species
TargetHSP90AA1
Overview
- SupplierGeneTex
- Product NameHsp90 alpha antibody
- Delivery Days Customer9
- Application Supplier NoteWB: 1:5000-1:20000. ICC/IF: 1:100-1:1000. IHC-P: 1:100-1:1000. IP: 1:100-1:500. *Optimal dilutions/concentrations should be determined by the researcher.Not tested in other applications.
- ApplicationsImmunoFluorescence, ImmunoPrecipitation, Western Blot, ImmunoCytoChemistry, ImmunoHistoChemistry, ImmunoHistoChemistry Paraffin
- CertificationResearch Use Only
- ClonalityPolyclonal
- Concentration0.27 mg/ml
- ConjugateUnconjugated
- Gene ID3320
- Target nameHSP90AA1
- Target descriptionheat shock protein 90 alpha family class A member 1
- Target synonymsEL52, HEL-S-65p, HSP86, HSP89A, HSP90A, HSP90N, HSPC1, HSPCA, HSPCAL1, HSPCAL4, HSPN, Hsp103, Hsp89, Hsp90, LAP-2, LAP2, heat shock protein HSP 90-alpha, HSP 86, LPS-associated protein 2, epididymis luminal secretory protein 52, epididymis secretory sperm binding protein Li 65p, heat shock 86 kDa, heat shock 90kD protein 1, alpha, heat shock 90kD protein 1, alpha-like 4, heat shock 90kD protein, alpha-like 4, heat shock 90kDa protein 1, alpha, heat shock protein 90kDa alpha (cytosolic), class A member 1, heat shock protein 90kDa alpha family class A member 1, heat shock protein family C member 1, lipopolysaccharide-associated protein 2, renal carcinoma antigen NY-REN-38
- HostRabbit
- IsotypeIgG
- Protein IDP07900
- Protein NameHeat shock protein HSP 90-alpha
- Scientific DescriptionHSP90 proteins are highly conserved molecular chaperones that have key roles in signal transduction, protein folding, protein degradation, and morphologic evolution. HSP90 proteins normally associate with other cochaperones and play important roles in folding newly synthesized proteins or stabilizing and refolding denatured proteins after stress. There are 2 major cytosolic HSP90 proteins, HSP90AA1, an inducible form, and HSP90AB1 (MIM 140572), a constitutive form. Other HSP90 proteins are found in endoplasmic reticulum (HSP90B1; MIM 191175) and mitochondria (TRAP1; MIM 606219) (Chen et al., 2005 [PubMed 16269234]).[supplied by OMIM]
- ReactivityDrosophila, Human, Monkey, Mouse, Rat, Other Species
- Storage Instruction-20°C or -80°C,2°C to 8°C
- UNSPSC12352203
References
- Lu SH, Wu YH, Su LY, et al. Cardiac myofibrillogenesis is spatiotemporally modulated by the molecular chaperone UNC45B. Stem Cell Reports. 2023,18(7):1405-1420. doi: 10.1016/j.stemcr.2023.05.006Read this paper
- Lista MJ, Ficarelli M, Wilson H, et al. A Nuclear Export Signal in KHNYN Required for Its Antiviral Activity Evolved as ZAP Emerged in Tetrapods. J Virol. 2023,97(1):e0087222. doi: 10.1128/jvi.00872-22Read this paper
- Lista MJ, Winstone H, Wilson HD, et al. The P681H Mutation in the Spike Glycoprotein of the Alpha Variant of SARS-CoV-2 Escapes IFITM Restriction and Is Necessary for Type I Interferon Resistance. J Virol. 2022,96(23):e0125022. doi: 10.1128/jvi.01250-22Read this paper
- Pariollaud M, Ibrahim LH, Irizarry E, et al. Circadian disruption enhances HSF1 signaling and tumorigenesis in Kras-driven lung cancer. Sci Adv. 2022,8(39):eabo1123. doi: 10.1126/sciadv.abo1123Read this paper
- Song X, Wang Y, Li F, et al. Hsp90 Inhibitors Inhibit the Entry of Herpes Simplex Virus 1 Into Neuron Cells by Regulating Cofilin-Mediated F-Actin Reorganization. Front Microbiol. 2021,12:799890. doi: 10.3389/fmicb.2021.799890Read this paper
- Yuan H, Suzuki S, Hirata-Tsuchiya S, et al. PPARγ-Induced Global H3K27 Acetylation Maintains Osteo/Cementogenic Abilities of Periodontal Ligament Fibroblasts. Int J Mol Sci. 2021,22(16). doi: 10.3390/ijms22168646Read this paper
- Winstone H, Lista MJ, Reid AC, et al. The Polybasic Cleavage Site in SARS-CoV-2 Spike Modulates Viral Sensitivity to Type I Interferon and IFITM2. J Virol. 2021,95(9). doi: 10.1128/JVI.02422-20Read this paper
- Ono K, Sogawa C, Kawai H, et al. Triple knockdown of CDC37, HSP90-alpha and HSP90-beta diminishes extracellular vesicles-driven malignancy events and macrophage M2 polarization in oral cancer. J Extracell Vesicles. 2020,9(1):1769373. doi: 10.1080/20013078.2020.1769373Read this paper
- Lin TY, Hua WJ, Yeh H, et al. Functional proteomic analysis reveals that fungal immunomodulatory protein reduced expressions of heat shock proteins correlates to apoptosis in lung cancer cells. Phytomedicine. 2021,80:153384. doi: 10.1016/j.phymed.2020.153384Read this paper
- Kok BP, Ghimire S, Kim W, et al. Discovery of small-molecule enzyme activators by activity-based protein profiling. Nat Chem Biol. 2020,16(9):997-1005. doi: 10.1038/s41589-020-0555-4Read this paper

![WB analysis of Hsp90 alpha and beta protein using GTX80037 Hsp90 antibody [MBH90AB].](https://www.genetex.com/upload/website/prouct_img/normal/GTX80037/GTX80037_20191028_WB_1_w_23061322_210.webp)
![IHC-P analysis of human colon carcicnoma tissue using GTX33995 Hsp90 alpha antibody [1F6]. Dilution : 1:200](https://www.genetex.com/upload/website/prouct_img/normal/GTX33995/GTX33995_20200622_IHC-P_296_w_23060801_795.webp)